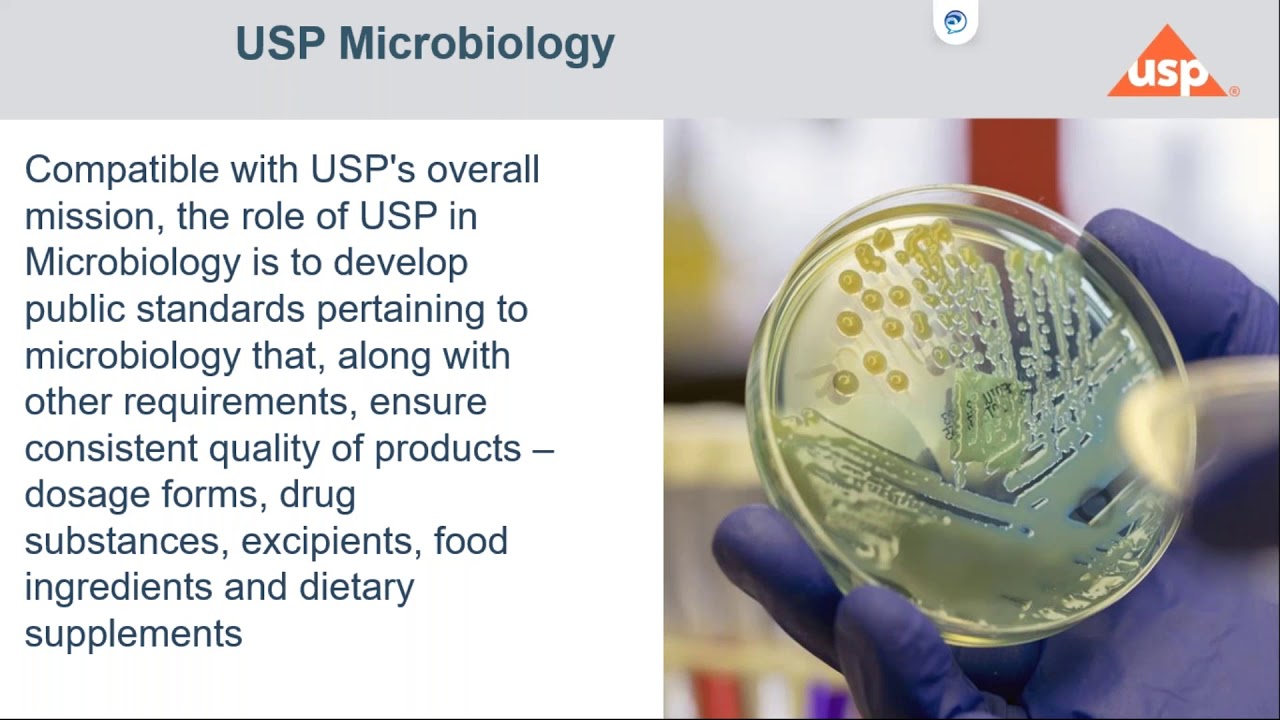
USP Methods for Microbial Contamination in Supplements, CBD Hemp and Probiotics

Microbial Limit test (MLT) Protocol, steps and procedure in Pharmaceuticals & cosmetics USP 61 & 62 скачать в хорошем качестве
Повторяем попытку...

Скачать видео с ютуб по ссылке или смотреть без блокировок на сайте: Microbial Limit test (MLT) Protocol, steps and procedure in Pharmaceuticals & cosmetics USP 61 & 62 в качестве 4k
У нас вы можете посмотреть бесплатно Microbial Limit test (MLT) Protocol, steps and procedure in Pharmaceuticals & cosmetics USP 61 & 62 или скачать в максимальном доступном качестве, видео которое было загружено на ютуб. Для загрузки выберите вариант из формы ниже:
-
Информация по загрузке:
Скачать mp3 с ютуба отдельным файлом. Бесплатный рингтон Microbial Limit test (MLT) Protocol, steps and procedure in Pharmaceuticals & cosmetics USP 61 & 62 в формате MP3:
Если кнопки скачивания не
загрузились
НАЖМИТЕ ЗДЕСЬ или обновите страницу
Если возникают проблемы со скачиванием видео, пожалуйста напишите в поддержку по адресу внизу
страницы.
Спасибо за использование сервиса ClipSaver.ru
Microbial Limit test (MLT) Protocol, steps and procedure in Pharmaceuticals & cosmetics USP 61 & 62
Full data and details about #Microbial_limit_test acc to European pharmacopeia 10th edition. The microbial limit test (MLT) is performed to assess how many and which of certain viable microorganisms are present in non-sterile pharmaceutical, healthcare or cosmetics manufacturing samples that range from raw materials to finished products. The test provides information about the safety of the tested product by determining if quantitative limits for certain microorganisms are exceeded. This video about Microbial Limit Testing (MLT) in pharmaceutical microbiology: 1. "Mastering Microbial Limit Testing in Pharma: Step-by-Step Guide" 2. "Microbial Limit Testing Explained: Key Concepts and Procedures" 3. "MLT in Pharma: Ensuring Safety and Compliance" 4. "Understanding Microbial Limits in Pharmaceuticals: MLT Demystified" 5. "Quality Control in Pharmaceuticals: The Importance of MLT" Detection of E. Coli, Salmonella Staphylococcus aerus and Pseudomonas aeruginosa in pharmaceutical products #Microbial_limit_test #Microbiology #Pharmaceutical_Microbiology #micro #qualitycontrol #pharmaceuticalmanufacturing #pharmaceuticalindustry #pharma #healthcare #laboratory #microlab #microbiologist #Elmicrobiologist 🔬 It covers testing for bile tolerant gram-negative bacteria as well as for Escherichia coli, Salmonella, Pseudomonas aeruginosa, Staphylococcus aureus, clostridia and Candida albicans. #Microbial_limit_test #Microbiology #Pharmaceutical_Microbiology